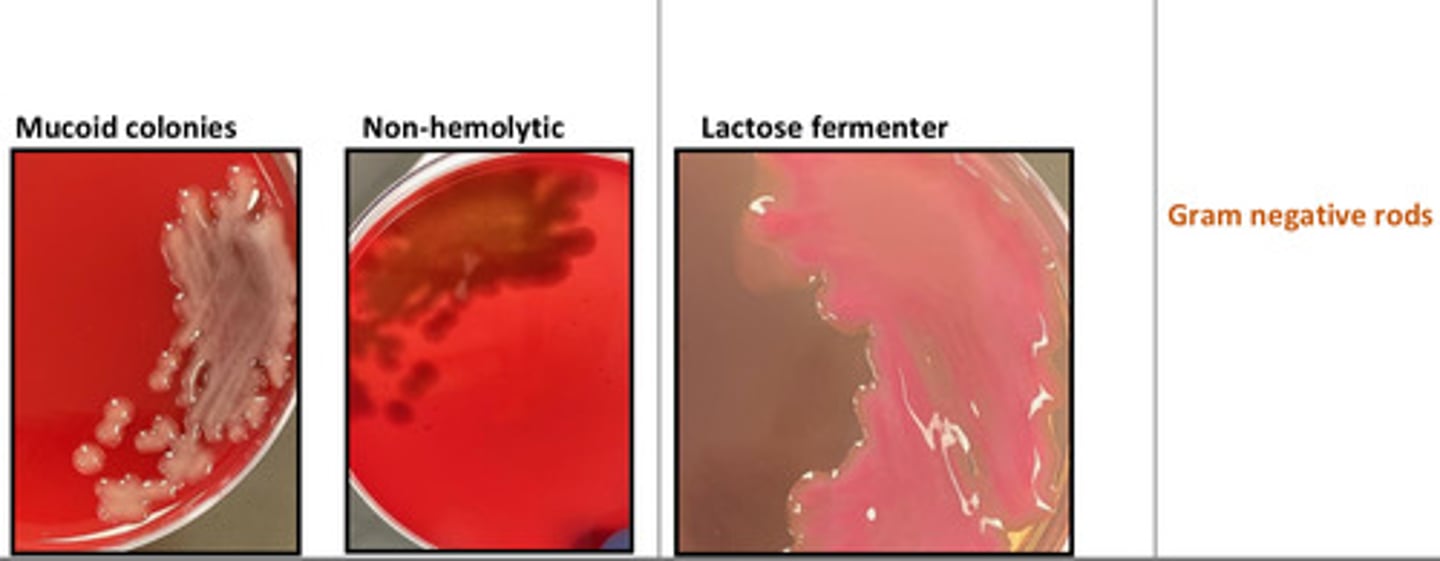
knowt flashcard image
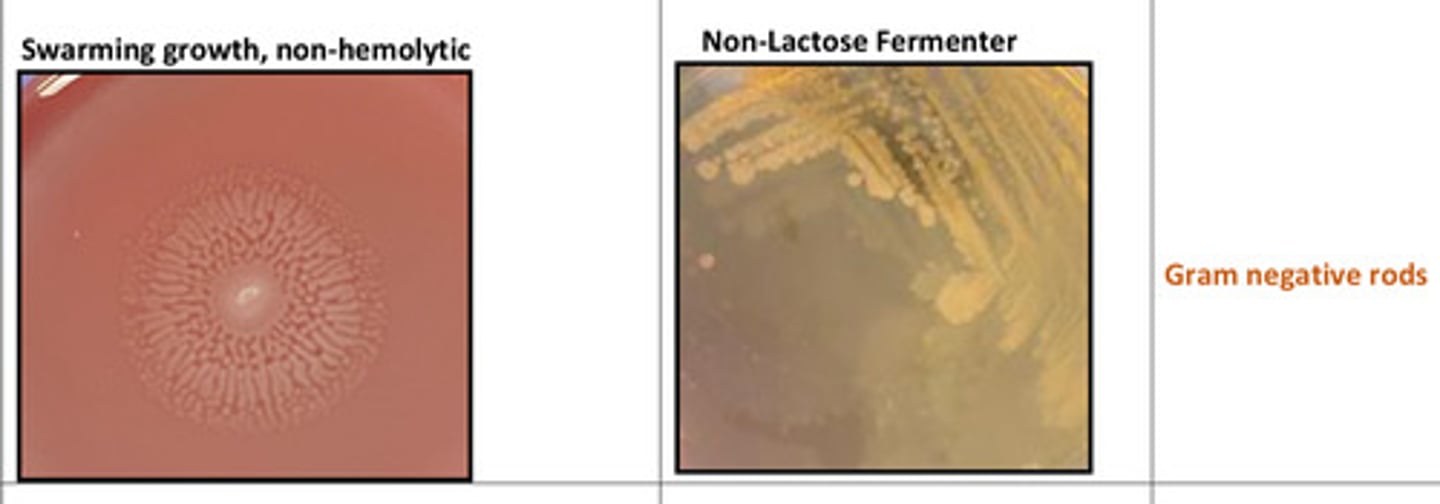
knowt flashcard image
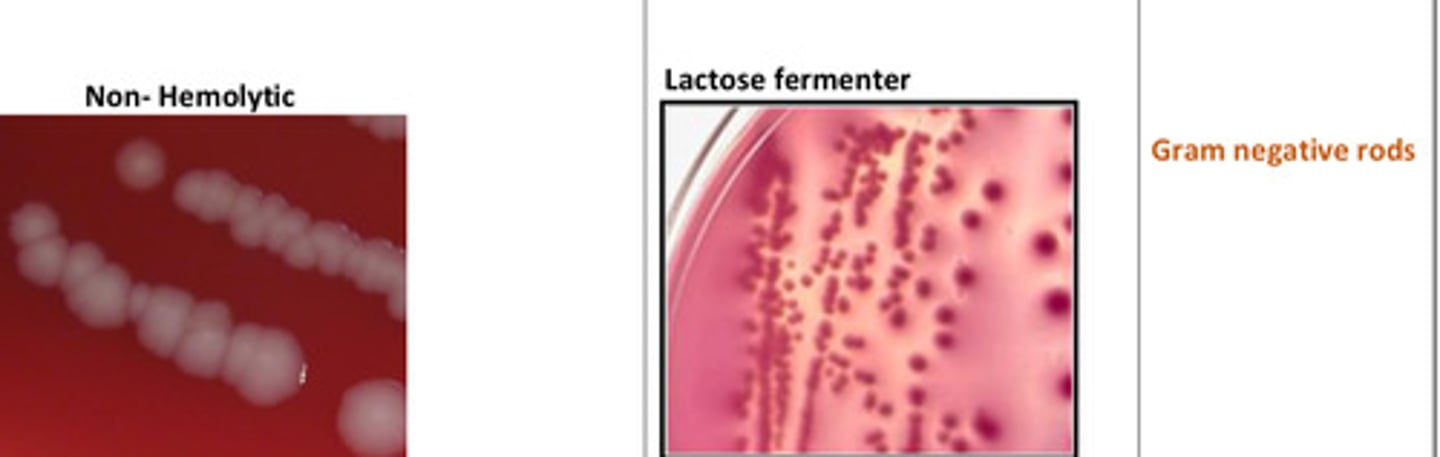
knowt flashcard image
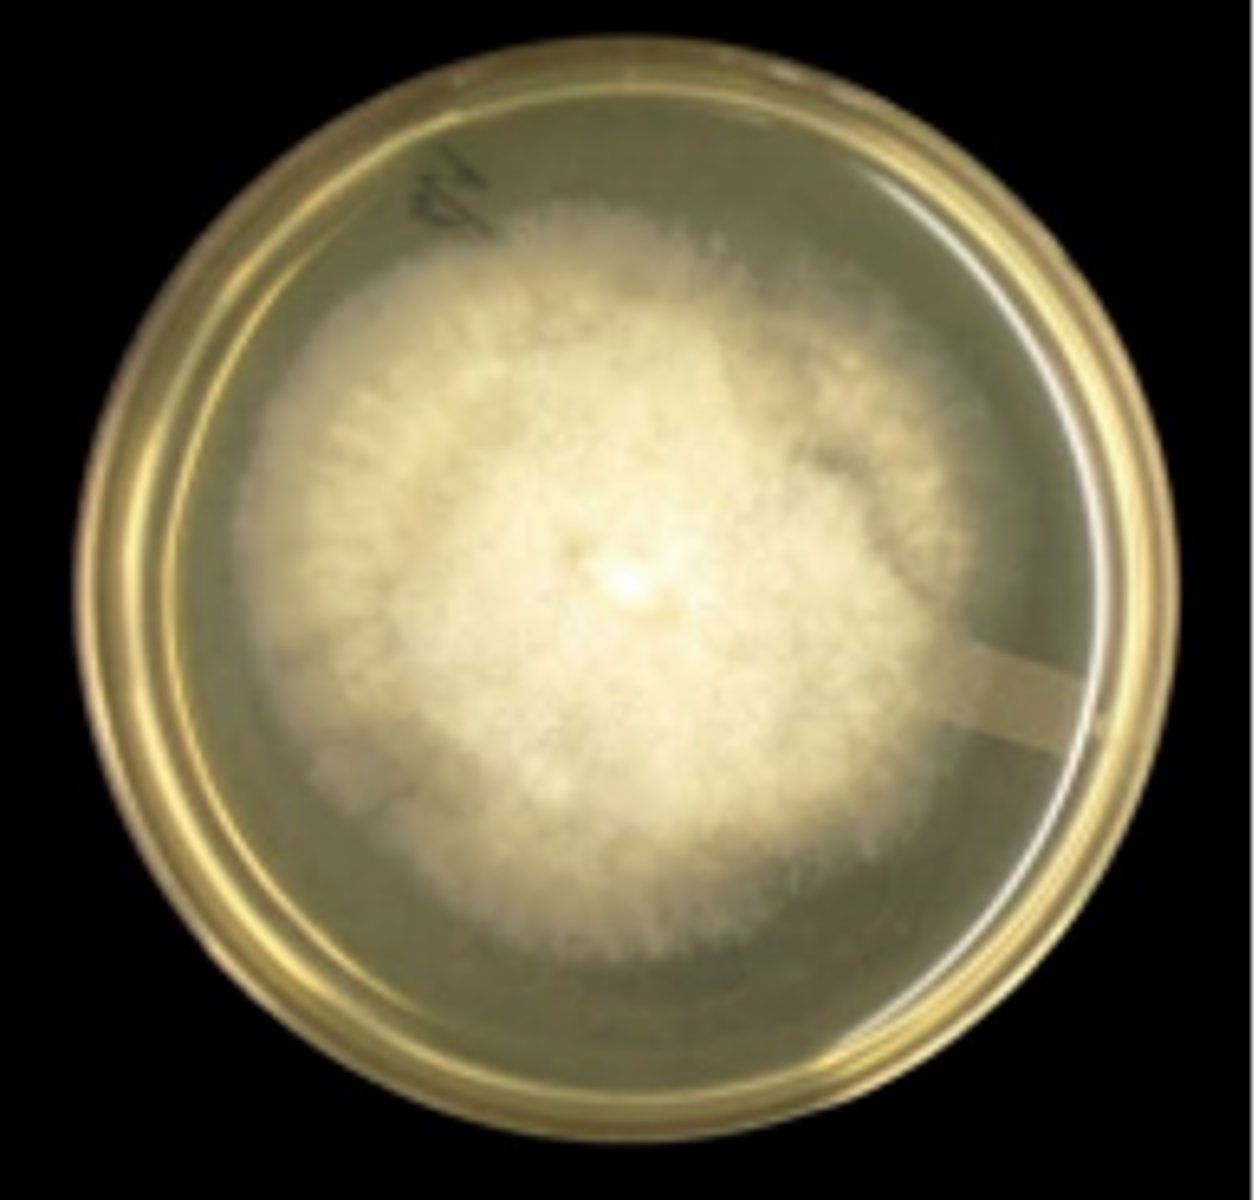
knowt flashcard image
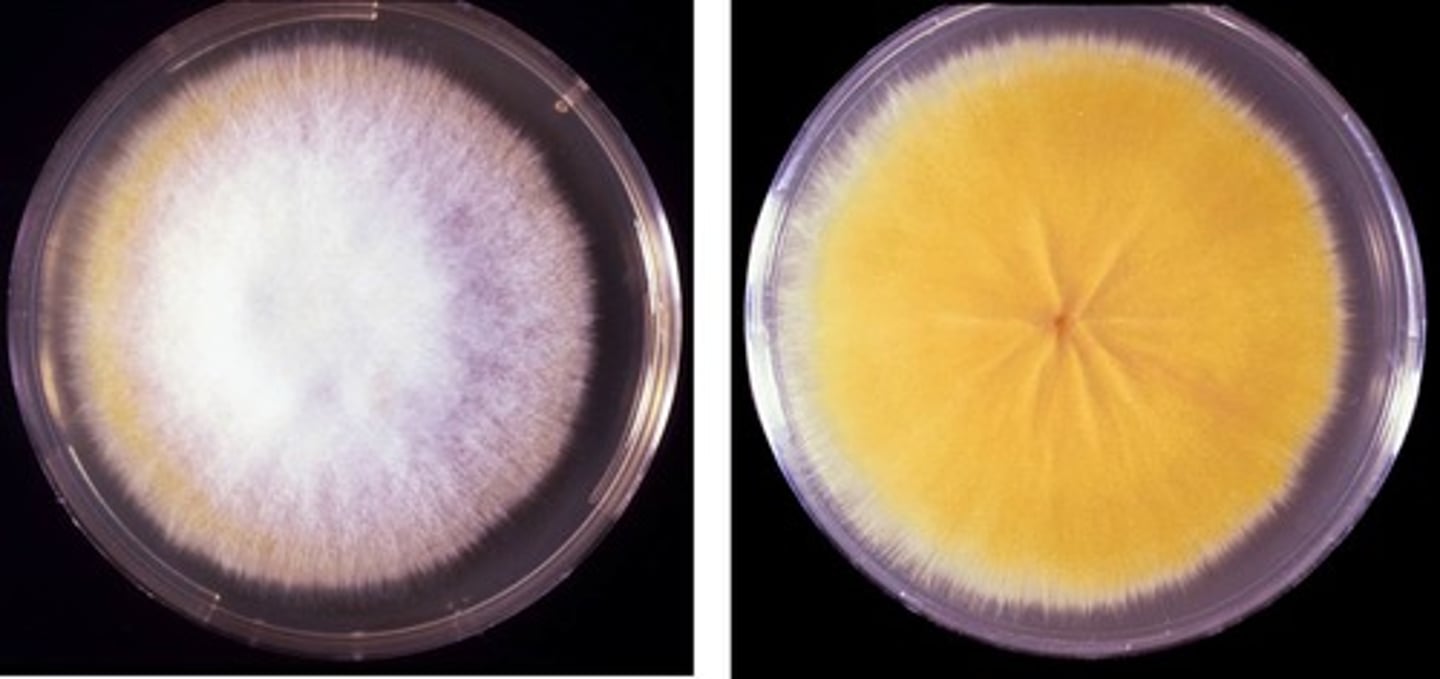
knowt flashcard image

Bacteriology Lab Final
1/46
There's no tags or description
Looks like no tags are added yet.
Name | Mastery | Learn | Test | Matching | Spaced |
|---|
No study sessions yet.
47 Terms
Klebsiella pneumoniae
Proteus mirabilis
Escherichia coli
Streptococcus equi subsp. zooepidemicus

Staphylococcus aureus

Staphylococcus pseudintermedius
A dog presented with pyoderma of the face and limbs. Material from pustules was plated on Blood (BA) and MacConkey (MAC) agars and incubated overnight at 350 C. BA plates are provided. There was no growth on MAC.
There is double zone hemolysis on BA, with small round opaque colonies
Gram stain shows gram+ cocci in clusters
It tests catalase and coagulase positive
What is the presumptive ID?
Streptococcus dysgalactiae subsp. dysgalactiae
An organism was isolated from a milk specimen of a Holstein cow with acute mastitis. The organism did not grow on MAC.
It appears weak greenish alpha-hemolysis with small transparent colonies
Presumptive ID?
Streptococcus agalactiae
An organism was isolated from a milk specimen of a Holstein cow with acute mastitis. The organism did not grow on MAC.
It appears on BA with a narrow zone of beta-hemolysis, and appears with small white colonies
What is your presumptive ID?
Staphylococcus hyicus
A BA plate culture from a case of acute exudative dermatitis in a recently weaned pig shoes no hemolysis, with small white colonies
There was no growth on MAC, and it is catalase and coagulase positive
Gram stain reveals gram+ cocci clusters
Presumptive ID?
Streptococcus equi subsp equi
This organism was isolated from a horse that developed a high fever and swollen submandibular lymph nodes several days after returning from a two-day riding event. The organism grew on BA but did not grow on MAC.
It appears beta-hemolytic.
What is your presumptive identification?
Streptococcus suis
Joint fluids from a few slaughter pigs showing signs of arthritis and/or valvular endocarditis were collected using sterile swabs and submitted for standard aerobic culture. BA and MAC plates were inoculated
It appears alpha-hemolytic on BA
There was no growth on MAC. What is your presumptive identification?
Campylobacter jejuni

Klebsiella pneumoniae

Nocardia
This organism was isolated from a mastitis case
It appears as filamentous gram+ rods, and forms spores from aerial filaments
Candida albicans
This organism was isolated from a mastitis case
It appears as gram+
It is a single-celled diploid, yeast-like fungus
Trueperella pyogenes
This organism was isolated from a mastitis case
It appears occasionally, and is opportunistic
It is gram+, has pleomorphic morphology
Hemolytic on BA
Prototheca zopfii
This organism was isolated from a mastitis case
It is an algae that lacks chlorophyll, and is important seasonal pathogen in the NE US
Pasteurella multocida
A young adult male cat was presented for clinical examination with a recent history of lethargy, inappetence, fever, and dyspnea. The cat also has a wound infection on his chest from a suspected cat fight a week ago.
What is the most likely organism?
Mannheimia haemolytica
Eight 12 month-old feedlot calves were quarantined with acute respiratory difficulties, one of which died despite treatment with a single dose long-acting antibiotic upon arrival at the feedlot. Post mortem findings showed extensive haemorrhagic fibrinous bronchopneumonia in the cranioventral lung lobes.
What is the most likely organism?
Bordetella bronchiseptica
A one-year-old male Labrador retriever presented with mild depression and recent history of a harsh, dry "honking" cough that appears to be exercise-related. The dog has a mild fever and palpation of the trachea elicited the cough. Further questioning of the owners revealed that their dog had been in a boarding kennel two weeks prior to becoming ill
Presumptive ID?
Actinobacilus equuli subsp equuli
. BA and MAC cultures from the kidney of a 4 day-old foal which died suddenly are provided. A Gram stained-smear prepared from colony material is also provided. On postmortem examination, there were multiple microabscesses in the kidneys
The organism in non-hemolytic on BA, and did not grow on MAC
Gram stain reveals gram- "morse code" rods
Corynebacterium renale
Urine sample from a cow with frequent urination, pyuria, hematuria and decreased milk production
Appears small yellow opaque colonies with no hemolysis on BA
Gram stain reveals pleomorphic gram+ bacteria
Likely ID?
Staphylococcus pseudintermedius
This bacteria was sent in for a urine culture from a dog collected by cystocentesis
It appears on BA with double zone hemolysis
Gram stain reveals gram+ cocci, coagulase test is postitive
Presumtive ID
Pseudomonas aeruginosa
A vet submitted swabs from sheep with exudative dermatitis (AKA "green wool disease", "fleece rot") for culture and identification. A bluish-green discoloration of the wool next to the areas of inflammation was noted. The organism isolated is gram-negative and oxidase positive
It has a distinctive odor and it is oxidase positive
It appears green on MAC
It has a metallic sheen appearance on BA
Presumptive ID?
Dermatophilus congolensis
Several scabs were collected and submitted for examination from a Holstein cow with raised scabs covering 20 to 30% of the back. Examination revealed a mild-moderate exudative dermatitis beneath the scabs. The scabs are 1-2 cm in diameter and with the hair entrapped, resemble a paintbrush when viewed from the side.
It did not grow on SDA or MAC
It appears on gram stain with gram+ branching filaments and a "train track" morphology
Clostridium tetani
A horse developed rigid extension of neck, back and limbs and an elevated tail head ("sawhorse stance")
The gram stain reveals distinctive gram-positive bacilli with terminal endospores; they resemble a tennis racket
Mucor (Zygomycetes)
A cow aborts late-term during the winter feeding period. Histology of placenta shows fungal elements stained brown/black with methenamine silver.You note broad (5-25 µm), aseptate hyphae with bulbous dilations, non-parallel walls, and wide-angle, non-dichotomous branching.
Likely ID?
Aspergillus fumigatus
A cow aborts; methenamine silver stain of the placenta shows fungal hyphae.You observe septate hyphae (3-6 µm) with parallel walls and dichotomous 45° branching, all the same width as the parent hypha.
Likely ID?
Aspergillus fumigatus
A dog with chronic unilateral nasal discharge has a BA culture that grows a characteristic green-grey colony. Tape prep reveals conidiophores with a vesicle and phialides, topped with chains of conidiospores
Likely ID
Microsporum canis
A dog presents with circular alopecic lesions. PAS-stained biopsy reveals fungi that stain bright pink. You note ectothrix arthroconidia surrounding hairs and pink hyphae outside and within follicles.
A culture on SAB-CC shows typical dermatophyte growth.LPCB mount reveals large, spindle-shaped macroconidia with rough, thick walls, 6-15 internal cells, and a terminal knob.
Likely ID?
Trichophyton verrucosum
A calf with crusty circular lesions has a KOH prep of plucked hairs.You observe arthrospores arranged around the hair shaft, though they may be difficult to visualize
Likely ID?
Candida albicans
A dog presents with mucosal lesions; culture on BA at 35°C grows cream-colored, shiny colonies
Gram stain reveals blue, budding yeast (3-5 µm) with daughters attached by a narrow base; occasional pseudohyphae may be present.
Likely ID?
Malassezia pachydermatitis
A dog with chronic otitis externa has a gram-stained ear swab showing peanut-, boot-print-, or bottle-shaped yeast (2-4 µm) with a broad base of budding.
Likely ID?
Cryptococcus neoformans
A cat with respiratory disease has H&E-stained lung tissue showing clusters of "soap bubbles" within inflammation.Inside the clear capsules, you find round yeast (3-15 µm) budding on a narrow base.
Culture on SAB at 35°C produces small, mucoid, cream colonies.India ink shows thick-capsuled yeast, with negative staining highlighting the halo.
Likely ID?
Coccidioides immitis
A dog with chronic cough and history of travel to Arizona has a PAS-stained lung biopsy showing huge spherules (20-200 µm) filled with endospores, surrounded by inflammation.
Likely ID?
Mucor

Mucor
Aspergillus

Aspergillus

Microsporum canis

Microsporum canis
Candida albicans

Malassezia pachydermatis

Cryptococcus neoformans

Histoplasma capsulatum

Blastomyces dermatitidis

Sporothrix schenckii
